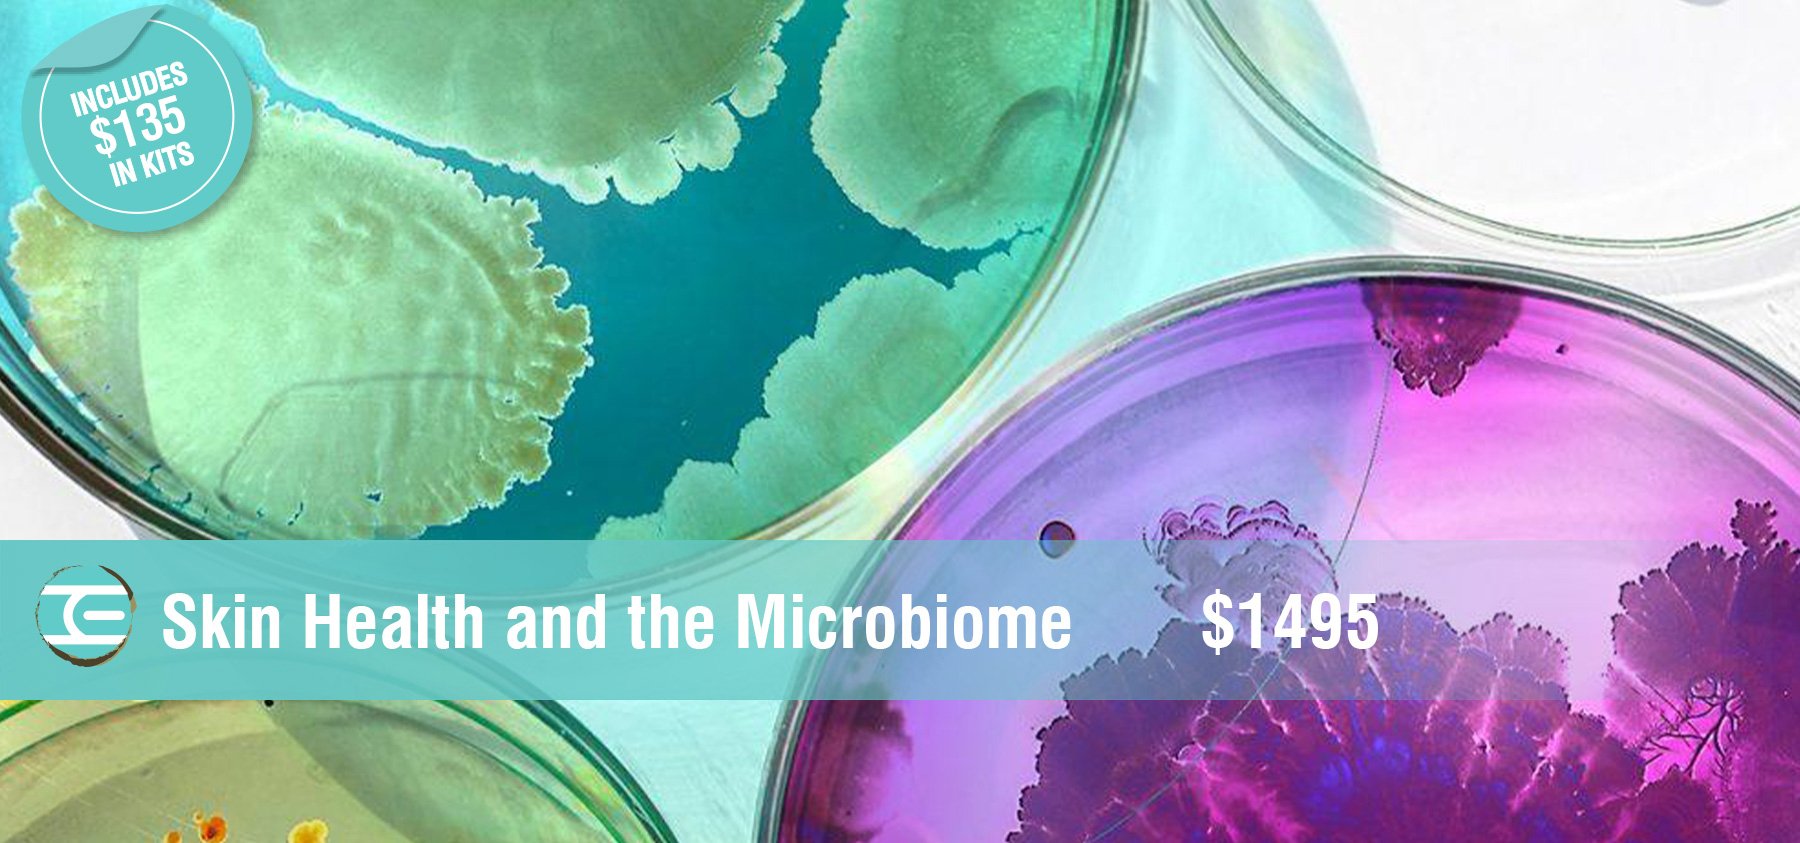

COURSE OPTIONS: ONLINE ONLY OR IN-PERSON FORMAT = THEORY & PRACTICAL IN-PERSON TRAINING
Certification: Facial Therapist
Includes: Training manual & student facial kit (value $358)
7 Days: Day 1 - 6 9:00am - 4:30pm
Day 7 - Exam 9:00am - 3:00pm
NOTE: ONLINE TRAINING OPTION ALSO AVAILABLE
*Please contact us for more information
This intensive certified Facial course includes training in bacteriology and sanitation, cell structure, muscle and skeletal systems, skin histology and physiology, disorders and diseases, skin type and skin condition evaluations, extractions, and massage. Students will learn differentiating techniques that add relaxation and nurturing to the facial. Procedures will focus on a basic deep pore cleansing facial with steam and extractions. Skincare products will be used for all skin types and conditions. In addition, you will be introduced to the use of high frequency. Models required. Quotas required.
ABOUT THE FACIALS LEVEL I COURSE
IN-PERSON OPTION
If you choose the in-person/classroom option, the entire 7-day course will be facilitated at one of our campuses and is under the instruction and supervision of our lead, skincare expert educator, Betty Ann Newton. An assistant will also be present in the class when the class size is between 8-10 students. Class size is capped at 10 students.
FACIALS LEVEL I ENHANCED ONLINE EXPERIENCE
Course Requirements – Students will be required to have a webcam (available for purchase if applicable) and be prepared with a set up for practical experience (a list of required supplies and equipment will be provided at the time of enrollment and in Moodle where you will access the online course)
Day 1 Live theory (9:00am - 4:30pm MT) – webinar on online training platform
Day 2 Live theory (9:00am - 4:30pm MT) - webinar on online training platform
Day 3 (AM) Explanation of equipment used and Live demo
(PM) Students to work on a model with step-by-step instructions (model time 1pm MT)
Day 4 (AM) Theory exam review
(PM) Students will work on models with step-by-step instructions and real-time
feedback to help improve on techniques (model times 1pm & 2:30pm MT)
Theory will be interactive and will require students to be in a quiet place with no distractions. A manual will be provided on the online platform prior to the live session for students to save and use as a resource. You will also receive a printed copy of your manual with your student kit.
Following the 4 days of live webinars, students will have at least 2 weeks to complete 6 facial practicals as part of their course and to aid in studying. A list of items recommended for students to have to facilitate their practical facials at home will be provided at time of registration and on the online platform. A kit containing all skincare required for facials will be provided and is included in the course fee.
Your scheduled exam date indicates the deadline for class so you will be required to submit your 6 quotas forms to your Google Drive and when your theory exam becomes available on Moodle, you are welcome to take the exam. A full video of your facial service is required for the final practical exam so please ensure you have a model arranged and have a phone, laptop or computer webcam to film the entire service; more detailed instructions will be provided upon enrollment. Students must have a gmail account to access the online platform.
"It was truly an honour to be taught by Betty Ann Newton. She is by far the most wonderful teacher I've ever had (and I've completed a few degrees) Every part of my course was incredible. Thank you so much! I honestly don't think there is anything I would add or change. It was excellent from first inquiring with Vanessa to signing up and then completing the course."
Zoe
“It was great, Betty-Ann was very knowledgeable and beyond just the facials aspect, she knows so much more about skin! Thoroughly enjoyed each class and the products in the kit are great and good to use on everyone.”
Kelsey
Common Questions
When can I take this course? Both the online and in person option is offered at least once a month. Both options start on the same day.
Is anything included in this course in terms of kits and manuals?
The Facials Level I course includes a comprehensive professional facial kit, valued at $325! Students also must have a white Esthetician jacket to participate in this class along with professional attire. These are available for purchase through us.
How is the course structured?
Please review the course outline for a detailed description of how the class is structured in person. Online only students only participate live for the first two days and final exam. They must complete the required practicum to be eligible to participate in the exam.
What are the quotas/practicum associated with this class?
Regardless if you do the class in person or online, all students must complete 6 practical facial practicum on clients, which may be friends or family.
Practicum may be completed outside of the school with the student kit provided. Alternatively, students are welcome to use our student quota room at our south campus. This must be booked with our administration team.
How is the final exam structured?
In Person Students: The final exam is from 9am to 3pm for in person students. The exam consists of a 2 hour theory exam and a 1.5 hour practical exam. A model is required for the practical exam.
Online Only Students: Online students will take their final theory exam from 9-11am on the day it has been scheduled. This will be proctored live with your educator.
The final practical facial must be videoed and submitted online on the exam day. Detailed instructions are given online once students are registered.
Our promise to all Online Option Students
TEI fully guarantees all online courses and programs! This means if you take one of our online courses and feel that you require additional support or training, you may come back to the school and take the entire practical portion in person, absolutely complementary.
FACIALS - LEVEL I
$2,495.00
PURCHASE YOUR RECOMMENDED ADDITIONAL SUPPLY LIST FOR FACIALS LEVEL I
“I am incredibly pleased with my experience for Facials Level l. The level of knowledge provided by my instructor was thorough and in-depth. I couldn’t have asked for a better teacher! All other staff were great as well (Emily, Andreea) with answering emails promptly and answering any questions I had. I’m excited to come back in June for the full program!”
-Ellison W.
COURSE OPTIONS: HYBRID OR ONLINE ONLY
Certification: Advanced Facial Therapist
Prerequisite: Facials Level I or Facial Therapist certification
Includes: Ultrasonic Skin Spatula, Radio Frequency LED 5-in-1 Device, Ice Globes, Repêchage Galvanic Hydrating Gel. Hybrid Kit value $209
Online Kit - Includes: Ultrasonic Skin Spatula, Radio Frequency LED 5-in-1 Device, Ice Globes, Repêchage Galvanic Hydrating Gel, and a product kit with several individual Repêchage professional skin care treatments, a rubber bowl, a fan brush, and a spatula. Online Kit value $465.
3 Days: 9:00am - 4:30pm + Online Component (Hybrid Course)
This class is for those with basic facial certification who would like to expand on their existing knowledge of the skin and advanced treatment protocols to further address skin care concerns of clients. It will take your knowledge of the skin to a deeper level and prepare those entering the field of Medical Esthetics. The course includes knowledge and experience of Repéchage skincare treatments and their Medical Esthetic Program. Theory will include a study of the circulatory, lymphatic and nervous system and how it relates to the skin and body functions. Students will also gain a thorough understanding in the uses of electrotherapies including rotary brush, suction, Lucas Pulverizer, high frequency, galvanic, ultrasonic skin scrubber and the use of LED.
HYBRID OPTION
In this Advanced Facials Level ll Hybrid class, students will receive online course access 2 weeks prior to their in-person practical and will have adequate time to review theory and supporting resources. The course commences with a comprehensive advanced theory lecture. Following this, students will watch and study two professionally recorded videos demonstrating the use of multiple electrotherapies as well as an acclaimed Répechage skincare treatment. Students are required to pass two competency quizzes, which include a detailed skin review and electrotherapy. 2 Models with skin conditions are required.
ONLINE OPTION
Students are required to have a computer with a webcam and mic or a laptop to join your instructor live through Moodle for 4.5 hours. During this review, students can expect to go through the theory they have learned and a question-and-answer session. The lead skincare educator will lead attendees through a live, complete step-by-step advanced facial on a model using the equipment modalities and supplies provided in the student kit.
Students will be required to have a model to practice on during this session to demonstrate their skill set and knowledge of advanced modalities. Model times will be confirmed once registered for the course. Each student will be required to have a facial set up, which includes a bed dressed to receive a model and a table for supplies. In this class, each candidate will be encouraged to write their own protocol based on the client’s skincare needs.
DAY 1 9:00am - 1:00pm MT Review of theory, live demo and hands-on practical
(model required)
Theory will be static and will be available to review 14 days before the scheduled live 4.5-hour webinar. A manual will be provided on the online platform prior to the live session for students to save and use as a resource. You will also receive a printed copy of your manual with your student kit.
Our promise to all Online Option Students
TEI fully guarantees all online courses and programs! This means if you take one of our online courses and feel that you require additional support or training, you may come back to the school and take the entire practical portion in person, absolutely complimentary.
FACIALS LEVEL II - ADVANCED
$1,995.00
PURCHASE YOUR RECOMMENDED ADDITIONAL SUPPLY LIST FOR FACIALS LEVEL II
“The instructor was incredible - very nurturing, informative, gentle and helpful! Marnie led the class so well, allowing us freedom to cultivate our own facials for our models which I loved. I have thoroughly enjoyed this class.”
Trinity Lyons
“Both instructors were very knowledgeable and quick to answer all our questions. I felt very supported through the class.”
Kayla Maclean
“Janay Ontkean was an absolute pleasure to learn from. I can't reiterate enough the level of respect, consideration and kindness I received from her. She was so hands-on and showed me so many techniques to aid in my future. She was extremely informative, going out of her way to find out any information we needed in class. I just want to thank the Institute for blessing me with the opportunity to have been taught by her in Facials Level Il because she was absolutely phenomenal. Thank you once again!”
Alexis
“As always I’m leaving class feeling prepared and excited to offer new treatments to my clients. The kit for this class was amazing!”
Kayla Maclean
COURSE OPTIONS: IN-PERSON FORMAT = THEORY & PRACTICAL IN-PERSON TRAINING
Certification: Skin Health and the Microbiome
Includes: Training manual & student kit (value $135)
3 Days: Day 1 - 3 9:00am - 4:30pm
The science of rewilding skin: A healthy microbiome is essential to keep skin looking younger for longer. Rewilding is the science of returning skin to its balanced and “wild” state through biotechnology. This helps create the environment for your skin’s natural microbes to flourish, restoring its ecology.
Your microbiome is an ecosystem of billions of diverse microbes that protect skin from pathogens. Similar to your gut, these bacteria, fungi and viruses have essential roles in protecting you and educating your immune system. They also help skin produce Hyaluronic Acid and other moisturizing factors, while maintaining the skin’s pH and helping produce calm, healthy skin that not only looks better but ages slower. Skin is the largest organ of the human body. It is essential to look after it.
Our modern lifestyles don’t do our microbial partners any favors. Less contact with nature than our ancestors had, results in less microbial diversity. Using industrial beauty products with surfactants and parabens, strips our microbiomes. The result is a massive increase in sensitive skin, acne and other skin problems. Biotechnology is the answer
A sustainable solution in scientifically proven organic biotechnology to create an environment on skin that allows natural microbial diversity to return and thrive. Probiotics and prebiotics in organic formulations help restore the balance in a process we call “rewilding” – resulting in younger and healthier looking skin. Probiotics & prebiotics: Probiotics are live microbes that can shift the skin’s ecology to favor a diverse ecosystem healthy enough to resist attacks from pathogens. They also slow the skin’s rate of aging by reducing inflammation and seeds the skin with probiotics and feeds the skin with prebiotic nutrients to ensure a microbial intervention that balances the skin’s ecology.
Join the Esthetic Institute for an intensive 3 day class on Microbiome and skin health. Learn why our microbiome has been compromised, what healthy microbes are vs pathogens, learn what ingredients support skin's ecological system to bring it back to a healthy state so that we age slower, have less reactions, to improve acne and pigmentation. You will have an opportunity to experience a shift in your microbiome, to have hands-on experience so that you may help your client improve the health of their skin.
SKIN HEALTH AND THE MICROBIOME
$1,495.00
The science of rewilding skin: A healthy microbiome is essential to keep skin looking younger for longer. Rewilding is the science of returning skin to its balanced and “wild” state through biotechnology. This helps create the environment for your skin’s natural microbes to flourish, restoring its ecology.
Your microbiome is an ecosystem of billions of diverse microbes that protect skin from pathogens. Similar to your gut, these bacteria, fungi and viruses have essential roles in protecting you and educating your immune system. They also help skin produce Hyaluronic Acid and other moisturizing factors, while maintaining the skin’s pH and helping produce calm, healthy skin that not only looks better but ages slower. Skin is the largest organ of the human body. It is essential to look after it.
“This class was so informative! Mel and Betty Ann made sure all my questions were answered accurately.”
-Hamida V.
“Mel and Betty Ann did an awesome job delivering this course. I enjoyed every bit of it. Thank you!”
-Samina Q.
“Great class. Learned a lot and feel very informed in making good choices for gut and skin health.”
-Ashley K.
COURSE OPTIONS: ONLINE ONLY
Certification: Skin Care Ingredients
Prerequisite: Facial Therapist or Esthetician
1 Day Online Certification Course
NOTE: THIS COURSE IS TAUGHT EXCLUSIVELY ONLINE.
Students will have 21 days to complete this online course from the selected start date.
This online workshop is a must for beginner and advanced Estheticians to gain a thorough knowledge and understanding of the composition of skin care products. Having a thorough comprehension of skin care ingredients will benefit professionals in making informed decisions of product recommendations for their clients. This workshop will identify why it is essential to understand skin care products including chemistry, ingredients and selection. In addition, students will gain knowledge of ingredients recommended for specific skin care problems. Walk away from this workshop with significantly more confidence in your skin care ingredients education!